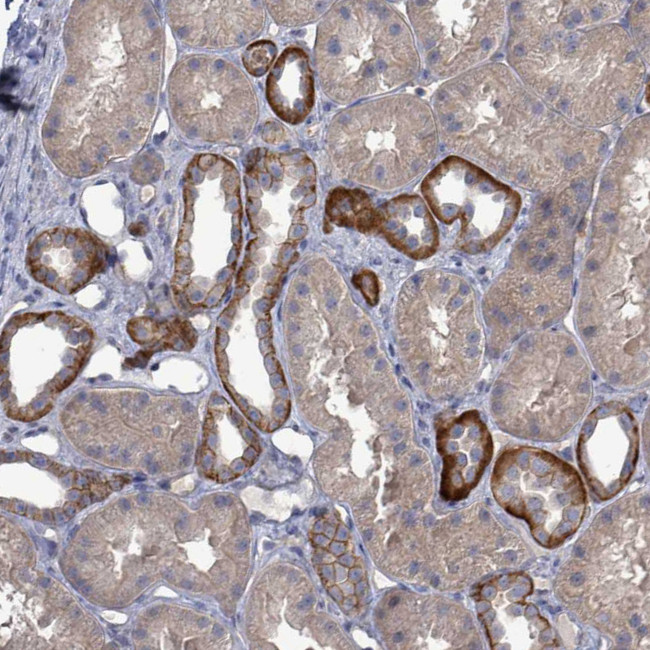
K-Ras Antibody in Immunohistochemistry (Paraffin) (IHC (P))

Search
Invitrogen
K-Ras Polyclonal Antibody
{{$productOrderCtrl.translations['antibody.pdp.commerceCard.promotion.promotions']}}
{{$productOrderCtrl.translations['antibody.pdp.commerceCard.promotion.viewpromo']}}
{{$productOrderCtrl.translations['antibody.pdp.commerceCard.promotion.promocode']}}: {{promo.promoCode}} {{promo.promoTitle}} {{promo.promoDescription}}. {{$productOrderCtrl.translations['antibody.pdp.commerceCard.promotion.learnmore']}}
产品信息
PA5-111300
种属反应
宿主/亚型
分类
类型
抗原
偶联物
形式
浓度
规格
纯化类型
保存液
内含物
保存条件
运输条件
RRID
产品详细信息
Immunogen sequence: EGFLCVFAIN NTKSFEDIHH YREQIKRVKD SEDV
Highest antigen sequence indentity to the following orthologs: Rat - 100%, Mouse - 100%.
靶标信息
K-RAS (GTPase KRas) belongs to the Ras oncogene family. Ras proteins bind GDP/GTP and possess intrinsic GTPase activity. It plays an important role in the regulation of cell proliferation and has a role in promoting oncogenic events by inducing transcriptional silencing of tumor suppressor genes in colorectal cancer cells in a ZNF304-dependent manner. Mutations in the gene can result in leukemia acute myelogenous, leukemia juvenile myelomonocytic, Noonan Syndrome, gastric cancer, and cardiofaciocutaneous syndrome 2.
仅用于科研。不用于诊断过程。未经明确授权不得转售。
篇参考文献 (0)
生物信息学
蛋白别名: c-K-ras; c-Ki-ras; c-Kirsten-ras protein; c-ras-Ki-2 protein; cellular c-Ki-ras2; cellular c-Ki-ras2 proto-oncogene; cellular transforming proto-oncogene; GTPase KRas; K RAS; K-Ras 2; K-ras p21 protein; Ki-Ras; Kirsten rat sarcoma viral oncogene homolog; Kirsten rat sarcoma viral proto-oncogene; KRAS-ENOPH fusion; Kras-Enoph1 fusion protein; oncogene KRAS2; PR310 c-K-ras oncogene; PR371 c-K-ras oncogene; proto-oncogene GTPase; RASK; small GTP binding protein; transforming protein p21; unnamed protein product; v-Ki-ras2 Kirsten rat sarcoma 2 viral oncogene homolog
基因别名: 'C-K-RAS; C-K-RAS; c-Ki-ras; c-Ki-ras2; CFC2; K-Ras; K-Ras 2; K-RAS2A; K-RAS2B; K-RAS4A; K-RAS4B; KI-RAS; KRAS; KRAS1; KRAS2; NS; NS3; OES; RALD; RASK2
UniProt ID: (Human) P01116
Entrez Gene ID: (Human) 3845